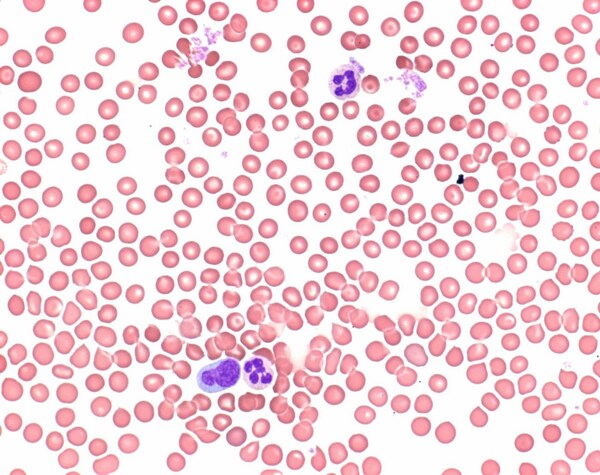
BR11013831002.jpg

* Imagem meramente ilustrativa
EOSINA AZUL DE METILENO SEG. WRIGHT MERCK
Modelo: BR11013831002
R$ 123,91
ou até 3x de R$ 41,30 sem juros
Economize 5% no PIX: R$ 117,71
ou 3,5% no boleto: R$ 119,57
Calcular Frete
Descrição
O método de coloração de acordo com Wright, é uma das técnicas padrão em procedimentos de diagnóstico hematológicas. Como solução de azul de metileno eosina de Leishman e solução de azul de metileno eosina de May-Grünwald, ele é usado para a coloração de sangue e medula óssea manchas e espécimes citológicos clínicos. Solução de azul de metileno eosina do Wright é um produto registrado IVD / CE e 500 ml são suficientes para a coloração até 1600 slides em células Hellendahl.
